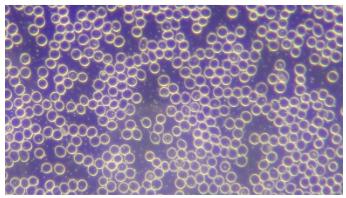

The clinic is in the process of being opened and will be fully functional in March 2025
Get your live blood examined with a high end dark field microscope to determine :

South Floridas Premiere Diagnostic, Detox and Healing Center for Long Covid and Issues caused by Toxins in Air, Food, Water and Injectables
is in the process of being opened and will be fully functional in March 2025 for:
The Problem
Intense research and study since 2021 into the causes of sudden deaths and severe illness has led to the discovery of toxic agents found in the air, food, water and certain injectable pharmaceuticals. Among these toxins are toxic metals such as Aluminum, Barium, Titanium but also Uranium, Tin, Nickel, Cesium and others. Another toxin discovered by various researchers using Raman Spectroscopy on injectable pharmaceuticals is Graphene Oxide. It‘s a massive free radical and inflammatory agent that destroys the membranes of cells and mitochondria, our power generators in cells. It was found to cause Chromosome and DNA breakage, spontaneous abortion, cancer, oxidation of red blood cells, neuromuscular issues, blood clots and other serious health issues. Graphene Oxide is a conductor of electricity and heat which is why it‘s used in the construction of nano circuitry. Other materials found in blood are hydrogel polymers such as from lipid nano particles like Polyethylene Glycol (PEG) found in the Covid vaccines, but also other polymers that are used in super glue and microplastics. Cultures of such polymers have been grown into macro sizes that are quite indestructible even by severely caustic agents. They require the presence of certain toxic metals though to begin the process of assembly which is why detoxing these metals is extremely important. Smart hydrogels respond to external stimuli like temperature, pH, light, magnetic and electric fields and enzymatic environment. They can and do combine with graphene oxide. Hydrogels can absorb water up to several thousand times their weight and swell. It can mold itself and take up the shape of the cavity it is in. Currently we suspect that hydrogels are part of the fibrous clots found by embalmers worldwide. They are regularly finding and pulling out white rubbery clots from blood vessels of the deceased that then continue to grow in the refrigerator.
These toxic substances affect many organ systems and also lead to death. In the cardiovascular system they cause myocarditis, heart attack, stroke, pulmonary embolism and blockages in other blood vessels such as the legs, arms, eyes, ears and so on. In the nervous system they cause seizures, Bell‘s palsy, Parkinson symptoms, Guillain Barre and most frequently, brain fog which really is brain damage. They impair fertility in men and women and can lead to spontaneous abortion. They suppress the immune system and enhance the growth of cancers. They cause dermatological issues including life threatening blistering. They increase susceptibility to Auto-Immune diseases such as Arthritis and Graves Disease.
The Other Problem
As if the aforementioned health issues weren‘t enough, there is another major problem these toxins bring about for humanity.
An article in ACS Publications from 2007 discusses how smart nanomaterials, called Mesogens which have characteristics of liquid crystals can use PEG to self-assemble nanofibrils. Mesogens are used to create whole body network interfaces for Artificial Intelligence bio sensing applications and remote mind control.
Diagnostics
The first step on the path of cleaning the body from these toxins is to find out if there is a problem and how bad it is.
The main diagnostic tool is live blood analysis using a high- end darkfield microscope with which the health of the blood cells can be evaluated and hydrogel polymers are made visible. Based on these findings as well as lab tests and a thorough history and physical examination, a treatment program can be tailored to each patient.
Treatments
At Doctors Detox we use a combination of well established treatments that have been around for many decades to clear the body of these toxins. We monitor treatment success with live blood analysis follow up. Once the blood is clear of these toxins, restorative treatments can be initiated.
Among the treatment modalities we use a variety of infusions from EDTA, to various vitamins, Glutathione and Plaquex as well as EBOO. The latter is ozone therapy that runs the blood through a dialytic filter to clear out some of the toxic substances. We also use a variety of oral dietary supplements tailored to each patients individual situation. Additional treatment modalities can include hyperbaric oxygen therapy and red and blue light therapy.
These treatments are not covered by health insurance. We work with care credit companies and do our best to keep the costs affordable to make these treatments accessible to most people who need them.
Schedule a consultation soon
We are located on the Campus of Palms West Hospital in Loxahatchee, FL near Wellington and Royal Palm Beach with easy access from the West Palm Beach Airport, I95 and the Turnpike.